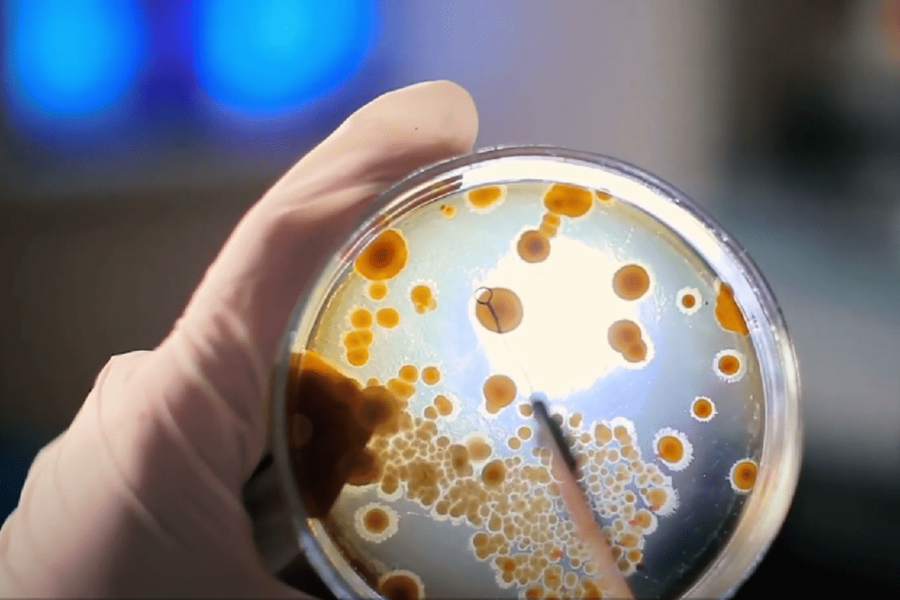

Bojan Glavašević neće u Europski parlament. Bio je šesti na listi SDP-a i osvojio 10.282 glasa. To mu nije dovoljno da bi dobacio do Bruxellesa. Stoga se na Facebooku oprostio od politike, ‘barem u ulozi kandidata na izborima’.
Objavu Bojana Glavaševića prenosimo u cijelosti:
Nakon što se nije nedavno plasirao ni u sabor, ostao je bez funkcije. Najavio je povlačenje iz politike.
“Dragi ljudi, hvala vam svima što ste bili uz mene u ovoj kampanji, ali i posljednjih 12 godina. U demokraciju sam uvijek vjerovao snažno i ta moja vjera nikada nije ovisila o tome gubim li izbore ili ih dobivam; i nije se umanjivala kada sam se suočavao s teškim trenucima, poput onih u kojima sam dobivao prijetnje i bio napadan.
Moja služba u politici, barem u ulozi kandidata na izborima, ovdje završava. Bila mi je čast!
‘U svakom porazu ja sam video deo slobode
I kad je gotovo
Za mene, znaj, tek tad je počelo’
Od srca vam hvala na podršci”, napisao je Glavašević na Facebooku.